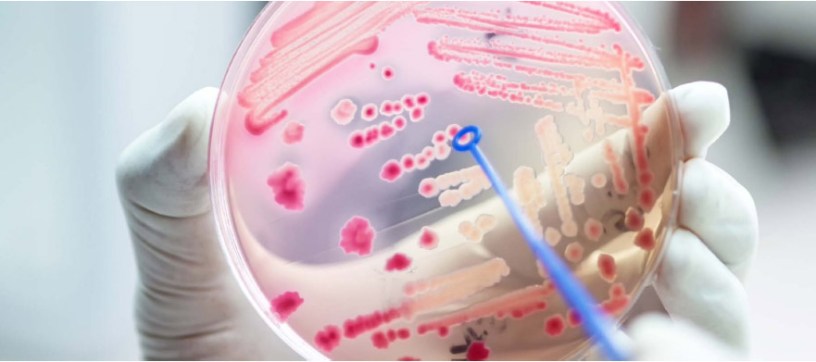

Si deseas adquirir un libro digital de medicina en archivo PDF, el precio por envío por unidad es a un costo mínimo. Contactos al número de WhatsApp o haz CLIC AQUÍ para más información. Te comparto el detalle de los libros en pdf. Puedes verlos, son solo muestras y no están completos. Una vez que puedas cancelar, te lo enviamos por WhatsApp o correo electrónico.
| Nombre | (Págs.) | (MB) | (Demo) |
|---|---|---|---|
| INFECTOLOGIA\ (10) | 640 | ||
| Enfermedades Infecciosas – Mandell Douglas Bennett – 7ma Edición.pdf | 4106 | 182 | PDFdemo |
| Enfermedades Infecciosas – Palmieri – Edición 2009.pdf | 754 | 412 | PDFdemo |
| Enfermedades Infecciosas en pediatria – Rudolph – 1era Edición.pdf | 351 | 12 | PDFdemo |
| Enfermedades infecciosas en UTI – Carrillo – 1era Edición.pdf | 411 | 3 | PDFdemo |
| Guia de tratamiento de urgencias infectologicas – Martinez – 3era Edición.pdf | 1007 | 8 | PDFdemo |
| Infecciones de transmision sexual – Casanova – 1era Edición.pdf | 529 | 4 | PDFdemo |
| Infecciones Respiratorias en Niños – Benguigui – 1era Edición.pdf | 503 | 3 | PDFdemo |
| Infectologia Clinica – Ramos – 2da Edición.pdf | 581 | 11 | PDFdemo |
| Patologias regionales y enfermedades emergentes – Gorodner – 1era Edición.pdf | 210 | 3 | PDFdemo |
| Temas de Infectologia – Cabrera – 1era Edición.pdf | 503 | 3 | PDFdemo |